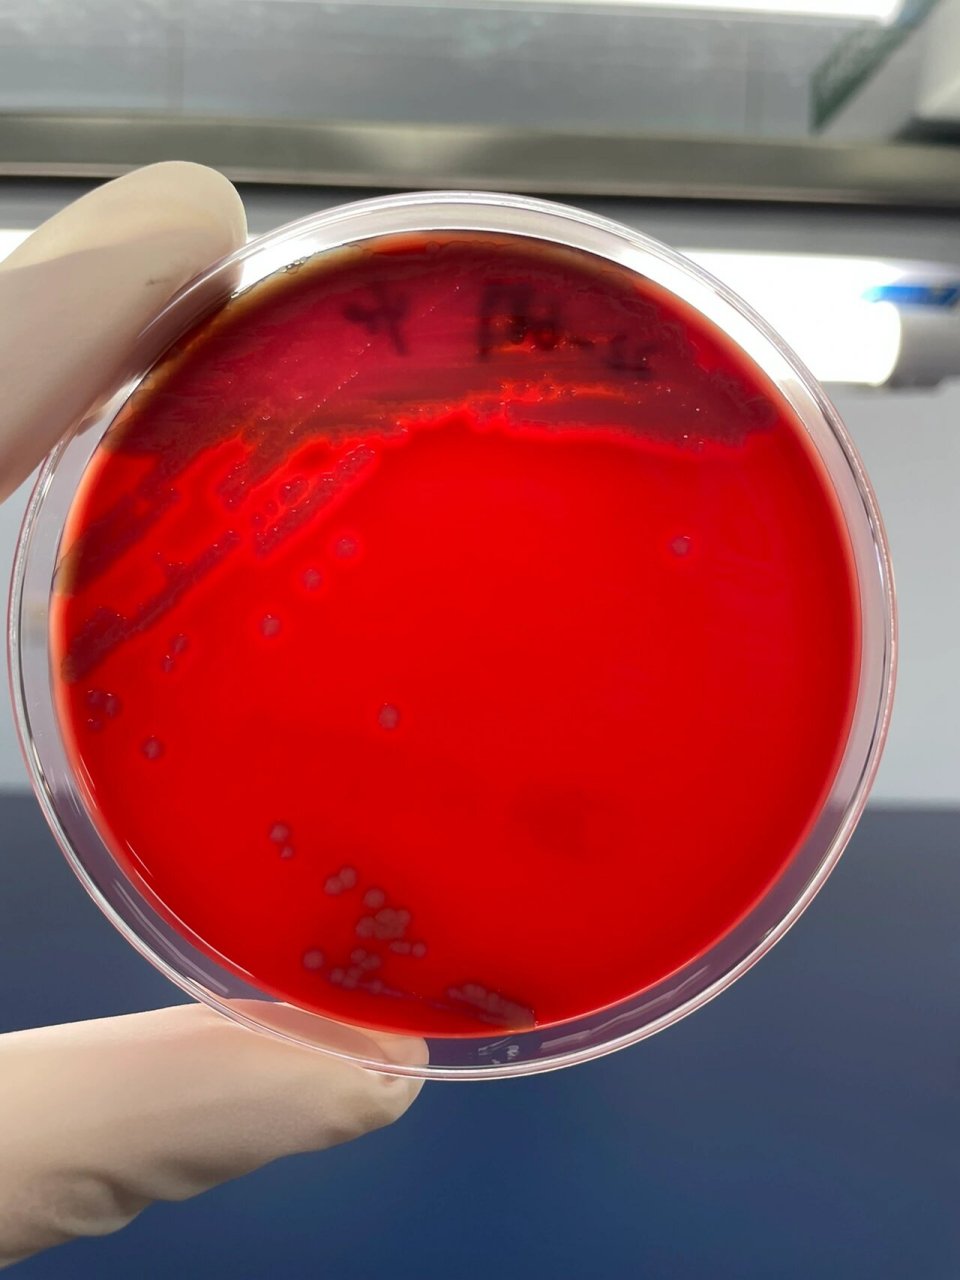
每日一菌-14 来源: 分离自粪便中的非o1群非o139群霍乱弧菌 图1:tcbs

霍乱 粪便

深夜科普|由武大出现霍乱病例所想到的
图片尺寸686x867
武汉新确诊霍乱很多妈妈收到疫苗接种提醒几岁可以去
图片尺寸640x400
从金坷垃到霍乱,粑粑如何影响人类文明进程?
图片尺寸1152x720
霍乱 鸡体温升高,鸡冠发紫,肉髯肿大,鼻流黏液,排出黄绿色粪 - 抖音
图片尺寸1440x1080
米汤样大便图片 米汤样大便是什么疾病
图片尺寸1242x828
硫磺水样粪便
图片尺寸1600x1200
禽霍乱禽霍乱用什么药?
图片尺寸578x358
每日一菌-14 来源: 分离自粪便中的非o1群非o139群霍乱弧菌 图1:tcbs
图片尺寸960x1280
粪便霍乱弧菌检测试剂(快检)
图片尺寸2000x1886
帮忙诊断这孔雀疾病,是霍乱?流感?传喉?还是混感?还是其它?
图片尺寸1037x692
水样便
图片尺寸768x1024
拉水样白色粪便
图片尺寸920x1632
霍乱时期没有爱情只有满大街的屎和尿
图片尺寸1080x1440
每日一菌-14 来源: 分离自粪便中的非o1群非o139群霍乱弧菌 图1:tcbs
图片尺寸960x1280
严重的霍乱患者会在粪便排放大量弧菌,这些弧菌游离在水中,通过饮食
图片尺寸576x306
本文告诉你_粪便_补充_问题
图片尺寸846x1166
每日一菌-14 来源: 分离自粪便中的非o1群非o139群霍乱弧菌 图1:tcbs
图片尺寸960x1280
"五颜六色"的粪便背后隐藏着什么?鸡粪又和肝脏疾病有怎样的联系呢?
图片尺寸1280x882
小孩2岁,大便每次都是羊粪,憋的满脸通红干结,诊断为体内水分不足.
图片尺寸690x1102
脾胃虚弱##脾胃##中医式生活
图片尺寸690x920